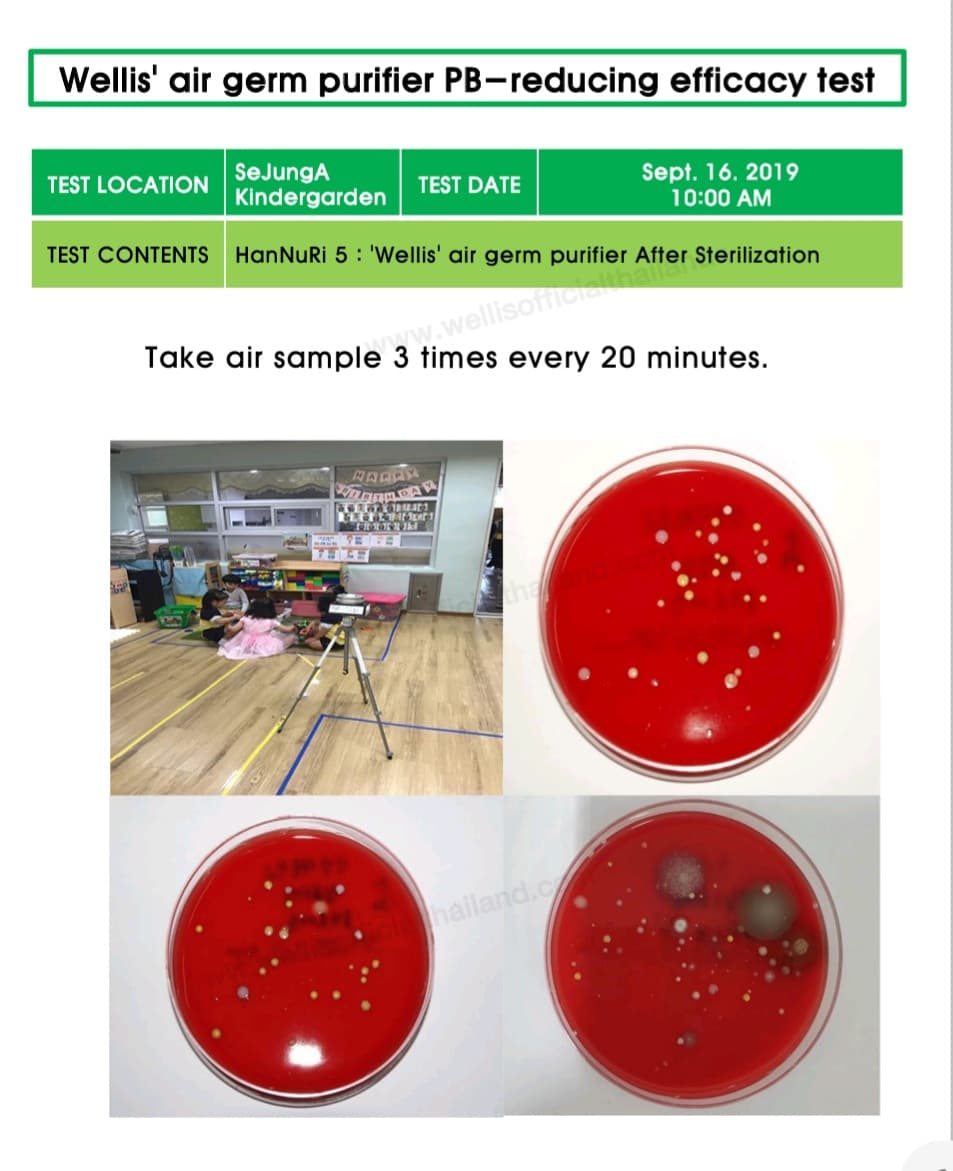

ด้วยโรคระบาด RSV และ Covid-19 ที่ยังแพร่ระบาดไม่หยุด ทางออกในปัจจุบันของผมที่อยากให้ลูกน้อยไม่ต้องเจ็บป่วยอีก คือต้องหาเครื่องฟอกอากาศเพิ่ม ! แต่เครื่องฟอกอากาศแบบเดิม ๆ ถ้าได้ศึกษามันจริง ๆ แล้วก็แทบจะไม่ต่างกัน
วันนี้หมวดหมีจะมาแนะนำเครื่องอากาศตัวใหม่ที่ไม่ใช้ไส้กรองแบบเดิม ๆ และไม่ต้องพึ่งพากับการไหลเวียนของอากาศ
นั่นก็คือเครื่องฟอกอากาศและฆ่าเชื้อโรค Wellis !

Wellis เป็นเครื่องฟอกอากาศและฆ่าเชื้อซึ่งนำเข้าจากประเทศเกาหลี ซึ่งโดยปกติเราจะเคยชินกับเครื่องฟอกอากาศแบบมีใช้ไส้กรองเป็นหลัก ซึ่งหลักการทำงานของมันง่าย ๆ คือ ดูดอากาศเข้าแผ่นกรอง และให้แผ่นกรองดักจับฝุ่นและเชื้อโรคต่าง ๆ ซึ่งประสิทธิภาพก็จะขึ้นอยู่กับแผ่นของไส้กรองที่ใช้ และเมื่อเราต้องเปลี่ยนไส้กรอง สุดท้ายตัวเราเองก็ต้องสัมผัสกับไส้กรองที่เป็นแหล่งรวมเชื้อโรคนั้นอยู่ดี
แต่ระบบของ Wellis นั้นแตกต่างออกไปจากยี่ห้ออื่น นั่นก็คือการใช้ระบบพ่นประจุ เพื่อกำจัดเชื้อโรคในอากาศและที่ติดอยู่ตามพื้นผิวต่าง ๆ ซึ่งเป็นสิ่งที่เครื่องฟอกแบบไส้กรองไม่สามารถทำได้ เพราะเครื่องฟอกอากาศแบบไส้กรองไม่สามารถดูดเชื้อโรคที่ฝังตัวอยู่กับวัสดุพื้นผิวต่าง ๆ ได้ ทำให้เชื้อโรคยังคงหลงเหลืออยู่ภายในอากาศ และพื้นผิวต่าง ๆ
นี่มันคือเครื่องฟอกอากาศเชิงรุก !
เพราะแทนที่มันจะตั้งรับแบบเครื่องฟอกอากาศแบบไส้กรองที่คอยดูดอากาศที่ไหลเวียนภายในห้องเพียงอย่างเดียว แต่ Wellis จะ “ปล่อย” ประจุไฮดรอกซิล ออกมาเพื่อทำปฏิกิริยาออกซิเดชั่นกับเชื้อโรคและสารพิษในอากาศ โดยตัวมันเองสามารถกำจัดได้ทั้ง ไวรัส , แบคทีเรีย และเชื้อรา ตัวอย่างเช่น RSV (ตัวเจ้าปัญหาของลูกน้อย) , ไวรัสโรต้า (ท้องร่วงและอาเจียนในเด็ก), ไวรัสมือเท้าปาก, SARS, MERS, วัณโรค, ไข้หวัดสายพันธุ์ต่าง ๆ รวมไปถึง ไวรัส Covid-19 ! (และยังมีเชื้อโรคอีกหลายชนิด โดยทางบริษัทมีผลทดสอบจาก Labs กับเชื้อโรคต่าง ๆ)
ไม่เพียงแต่เชื้อโรคเท่านั้นแต่ก๊าซพิษ สารพิษสารระเหยต่าง ๆ เช่น VOCs, NOx, Formaldehyde ซึ่งพบได้จากสีทาบ้าน ควันบุหรี่ ควันรถยนต์ และการเผาไหม้ต่าง ๆ (ซึ่งถ้าเคยอ่านดูรีวิวเก่า ๆ ของผม ผมจะเคยพูดถึงเรื่องอันตรายของสารประเภทนี้ ที่น่ากลัวพอ ๆ กันกับเชื้อโรค เพราะถึงแม้ว่าจะมองไม่เห็น สารบางตัวไม่ได้กลิ่น แต่ก็ใช่ว่าจะไม่มีอยู่จริง!) ซึ่งตัวเครื่องฟอกอากาศ Wellis ก็สามารถกำจัดได้ รวมถึงกลิ่นที่ไม่พึงประสงค์ ก็สามารถกำจัดได้เช่นกัน
แล้ว ไฮดรอกซิล ที่ใช้คืออะไรกันแน่ !?

ขอเกริ่นด้วยตารางเปรียบเทียบประสิทธิภาพในการทำปฏิกิริยา จากตารางจะเห็นได้ว่าประจุไฮดรอกซิล (OH-) มีประสิทธิภาพสูงกว่า Ozone , Hydrogen peroxide (น้ำยาฆ่าเชื้อในห้องผ่าตัด) และ คลอรีน ซึ่งสารเหล่านี้คือสารที่มีความสามารถในการฆ่าเชื้อโรคด้วยการทำปฏิกิริยาที่ผนังเซลล์ของเชื้อโรค
ซึ่งแต่เดิมตามธรรมชาติดวงอาทิตย์จะสร้างประจุไฮดรอกซิล (OH-) ขึ้น โดยประจุไฮดรอกซิลนี้สามารถกำจัดสิ่งสกปรกต่าง ๆ ได้ ซึ่งปกติแล้วประจุไฮดรอกซิลจะอยู่ในชั้นบรรยากาศในปริมาณ 200,000 – 8,000,000 ลบ.ซม. หลักการของประจุไฮดรอกซิล คือ เมื่อตัวประจุไปสัมผัสกับผนังเซลล์ของเชื้อโรคจะทำให้เชื้อโรคแตกตัว และผันตัวเปลี่ยนเป็นน้ำ (H2O) ส่งคืนกลับสู่อากาศ

โดยแรกเริ่มการทดลองการผลิตไฮดรอกซิลเพื่อกำจัดชีวมลพิษ ทดลองจากหลอด UVC แต่เนื่องจากหลอด UVC หากมนุษย์ได้รับโดยตรงอาจเป็นสาเหตุให้เกิดมะเร็งผิวหนัง และเป็นอันตรายต่อดวงตา ทำให้เกิดต้อกระจก และหลอด UV จะผลิต Ozone ออกมาด้วย ซึ่งหากมีปริมาณเกินกว่ามาตรฐานจะเป็นอันตรายต่อมนุษย์
คิดค้นวิธีที่ปลอดภัยจากสารสกัดธรรมชาติ
ต่อมา Dr.Pedro Monagas ผู้คิดค้น Wellis ก็ได้ทำการพัฒนาวิธีการผลิตประจุไฮดรอกซิลจากการใช้น้ำมัน Olefin จากส้ม Citrus California ซึ่งเป็นการสกัดจากธรรมชาติ โดยจะสามารถผลิตประจุ ได้เข้มข้นมากเทียบเท่ากับอากาศที่มีต้นไม้ขึ้นหนาแน่น ทำให้ปลอดภัยต่อคนและสิ่งมีชีวิตอื่น ๆ (เมื่อเราเปิดใช้งานเครื่องฟอกอากาศ Wellis จะได้กลิ่นส้มอ่อน ๆ เนื่องจากสารนั้นสกัดมาจากส้มนั่นเอง)

มาดูกันชัด ๆ กับหน้าตาและอุปกรณ์ของตัวเครื่อง

อุปกรณ์จะประกอบไปด้วย
1.ตัวเครื่องฟอกอากาศและฆ่าเชื้อ Wellis
2.น้ำมันโอเลฟิน จำนวน 1 กล่อง
3.ฐานเครื่องตั้งพื้น จำนวน 1 ชิ้น
4.ตัวแขวนและอุปกรณ์พุกติดตั้ง จำนวน 1 ชุด
5.สายไฟ
ข้อดีที่เห็นได้ชัดคือตัวเครื่องเล็กมาก ขนาดใหญ่กว่ากระดาษ A4 นิดหน่อย (กว้าง 22 ซม. ลึก 15 ซม. สูง 37 ซม.) และตัวเครื่องมีน้ำหนักที่เบามาก หนักเพียงประมาณ 1.3 กิโลกรัม จึงเคลื่อนย้ายได้สะดวก เหมาะสำหรับคนที่เลี้ยงลูกหลายห้องแบบผม

ถึงแม้ว่าจะตัวเล็กแบบนี้แต่ประสิทธิภาพในการทำงาน สามารถทำงานภายในห้องที่กว้างถึง 50 ตารางเมตร (ประมาณคอนโดห้องใหญ่ ๆ ห้องหนึ่ง)
สามารถติดตั้งกับฝาผนังได้เพื่อประหยัดพื้นที่ เนื่องจากมีพุกและอุปกรณ์แขวนมาให้ ซึ่งถึงแม้จะติดกับผนังก็ถอดออกได้ง่าย ๆ เพราะเหมือนขาเกี่ยวเครื่องไว้เฉย ๆ ไม่ได้มีตัวล็อคแน่น ดังนั้นการเคลื่อนย้ายก็สามารถทำได้ง่าย ๆ เพียงแค่ยกออก
การใช้งานก็ง่าย เพราะมีเพียงสองปุ่ม คือ ปุ่มเปิดปิดเครื่อง (Power Button) และ ปุ่มโหมดกลางคืน (Night Mode) ซึ่งในโหมดปกติเมื่อเปิดเครื่องเสียงเบากว่าแอร์ด้วยซ้ำ ทำให้ไม่รบกวนการทำงานและไม่ดึงดูดความสนใจลูกสักเท่าไหร่ และในโหมดกลางคืนตัวเครื่องจะปิดไฟสีสภาพอากาศและลดระดับการทำงานของเครื่องลง ทำให้เครื่องเงียบขึ้นมากกว่าเดิม ไม่รบกวนการนอนของผู้ใช้

รูปที่สองนับจากขวามือคือคำเตือนกรณีเกิดน้ำยาหมด และรูปขวามือสุดคือคำเตือนเมื่อใส่กล่องน้ำยาโอเลฟินผิดทาง หรือยังไม่ใส่กล่องน้ำยาโอเลฟิน หน้าจอก็จะโชว์ขึ้นมาเตือนดังรูป
บริเวณด้านหน้าตัวเครื่องจะแสดงแถบสีคุณภาพอากาศ ซึ่งวัดค่าสารประกอบอินทรีย์ระเหยง่าย (TVOC) ในขณะนั้น
- สีแดง – สภาพอากาศแย่
- สีส้ม – สภาพอากาศปกติ
- สีฟ้า – สภาพอากาศดี
เมื่อเปิดใช้เครื่องใหม่ ตัวเครื่องจะเกิดไฟสีสลับกันไปมา ซึ่งเป็นขั้นตอนการวัดค่า TVOC หลังจากนั้นประมาณ 5 นาที จึงจะแสดงแถบไฟค่าสภาพอากาศปัจจุบันภายในห้อง

ช่องเล็ก ๆ ระหว่างแผงควบคุม และแผงไฟบอกสถานะ คือช่องที่ปล่อยประจุไฮดรอกซิลจากน้ำมันโอเลฟิน

น้ำมันโอเลฟิน นี้นำเข้าจากเกาหลีแท้ ๆ เป็นภาษาเกาหลีล้วน ห่อซีลอย่างดี
หน้าตาของตัวกล่องน้ำมันโอเลฟิน ด้านหน้าจะมีชิพสำหรับอ่านค่าอยู่ซึ่งเป็นฝั่งที่ต้องใส่เข้าไป ส่วนด้านท้ายจะมีที่จับตามรูปภาพช่วยให้จับง่ายเวลาใส่ และไม่ต้องห่วงว่าจะใส่ผิด ผมทดสอบลองใส่แบบ ผิด ๆ แค่เอาจ่อเข้าก็ยากแล้ว

บริเวณแถบด้านข้าง ขวาของตัวเครื่องมีแถบสังเกตปริมาณของน้ำยาน้ำมันโอเลฟิน โดยเมื่อเปิดเครื่องแถบจะขึ้นสีเขียวตามปริมาณน้ำยาที่เหลืออยู่ สามารถใช้ได้ 3 เดือน หากเปิดเครื่องตลอด 24 ชั่วโมง
แต่เนื่องจากตัวน้ำยาจะต้องเปลี่ยนใหม่ทุก 3 เดือนหลังจากเปิดใช้ เพื่อควบคุมคุณภาพของน้ำยา ถึงแม้ว่าจะใช้ไปแล้ว 3 เดือนน้ำยายังไม่หมด ก็จะไม่สามารถใช้ต่อได้
เปิดทั้งวันกินไฟแค่ไหนกัน ?
Wellis ถูกออกแบบมาให้เปิดใช้งานตลอด 24 ชั่วโมง ด้วยขนาดเครื่องใช้ไฟฟ้า 3.6 วัตต์ หากเปิดใช้งานติดต่อกัน 24 ชั่วโมง เป็นระยะเวลา 1 เดือน จะเสียค่าไฟประมาณ 6 บาท ต่อเดือนเท่านั้น! ดังนั้นบอกญาติผู้ใหญ่ว่าไม่ต้องกลัวเปลืองไฟ ไม่ต้องดึงปลั๊กออก (ผมโดนดึงประจำ ฮ่า ๆ)
ทำงานคู่กันกับเครื่องฟอกอากาศแบบไส้กรองได้ไหม?
การใช้งานควบคู่กับเครื่องฟอกอากาศแบบไส้กรอง ยังสามารถทำงานร่วมกันได้ แต่ควรวางไว้ให้ห่างกัน เพื่อไม่ให้น้ำยาของ Wellis ถูกดูดเข้าเครื่องฟอกอากาศแบบไส้กรองขณะทำงาน
มีผลการรับรองไหมว่าฆ่าเชื้อโรคได้จริง?
สำหรับใครที่อยากอ่านผลการทดลองเพิ่มเติมทาง Wellis ได้รวบรวมเอาไว้สามารถอ่านได้ที่นี่ครับ

เนื้อหาเป็นภาษาอังกฤษ ที่น่าสนใจคือมีผลการทดลองให้เห็นเปรียบเทียบกันเลยว่าสามารถลดการแพร่เชื้อและเจริญเติบโตของเชื้อโรคต่าง ๆ ได้จริง
ผ่านการรับรองมาตรฐานอะไรบ้าง?

- ได้รับการรับรองการผลิตที่ได้มาตรฐาน และความปลอดภัยของสหภาพยุโรป (CE Certificate)
- ได้รับการรับรองความปลอดภัย และประสิทธิภาพในการใช้งานจากองค์การอาหารและยาของสหรัฐอเมริกา (US FDA)
- ได้รับการรับรองความปลอดภัยจากสารอันตรายในเครื่องใช้ไฟฟ้า (RoHS)
- ได้รับการรับรองผลิตภัณฑ์อิเล็กทรอนิกส์ที่มีสัญญาณและคลื่นความถี่ที่ไม่รบกวนการสื่อสาร (FCC)
- ได้รับการรับรองมาตรฐานการจัดการด้านคุณภาพซึ่งครอบคลุมตั้งแต่การออกแบบ พัฒนา ผลิต และขาย เครื่องมือทางการแพทย์ (ISO 13485)
Wellis เหมาะกับใคร?
Wellis เหมาะกับ ผู้ป่วยที่ติดเชื้อง่าย ผู้สูงอายุ เด็กเล็ก และผู้ที่ต้องการให้ห้องที่พักอาศัยนั้นสะอาดปลอดเชื้อโรค เพื่อป้องกันการติดเชื้อต่าง ๆ ซึ่งในปัจจุบัน เครื่องฟอกอากาศตัวนี้ก็ได้นำมาใช้งานจริงในโรงพยาบาลและคลินิกหลาย ๆ แห่งในประเทศไทยแล้ว ดังนั้นหากนำมาใช้ในบ้านในยุคโควิดระบาดแบบนี้ก็ดูจะเหมาะกับสถานการณ์ที่สุด
สรุป
จากการศึกษาและการใช้งานจริงจากผม Wellis เป็นเครื่องฟอกอากาศเชิงรุก ที่เน้นไปทางฆ่าเชื้อโรคและสารพิษแบบ 10 เต็ม 10 เพราะด้วยหลักการที่กล่าวไปข้างต้น จริง ๆ แล้วมันสมควรที่จะถูกเรียกว่าเครื่องฆ่าเชื้อโรคในอากาศด้วยซ้ำ และเราไม่สามารถเอาไปเทียบกับเครื่องฟอกอากาศแบบใช้ ที่กรองฝุ่น HEPA ได้เลย เพราะมันคนละหลักการกัน ประกอบกับ Wellis ไม่สามารถกรองฝุ่น pm 2.5 ได้ จึงไม่สามารถนำมาเทียบกันได้ ในแง่ของการกำจัดฝุ่น

ด้วยหลักการทำงานของมันทำให้เครื่องมีขนาดเล็กและน้ำหนักเบา สามารถยกง่าย ย้ายง่าย เหมาะมากสำหรับคนที่เลี้ยงลูกหลายห้อง และสามารถเปิดใช้งานได้ทั้งวันทั้งคืนโดยที่ไม่ต้องกลัวว่าค่าไฟจะแพง เพราะกินไฟต่อเดือนประมาณ 6 บาท เท่านั้น แต่ต้องเปลี่ยนตัวน้ำมันโอเลฟินทุก 3 เดือน ซึ่งคิดค่าบำรุงรักษาต่อเดือนตกเพียงเดือนละประมาณ 416 บาท สำหรับบางสถานที่อย่างคลินิก , โรงพยาบาล หรือร้านต่าง ๆ ที่มีคนพบปะบ่อย และต้องการควบคุมการแพร่เชื้อโรคต่าง ๆ ก็นับว่าคุ้มกับสิ่งที่ได้รับ
ด้านนวัตกรรมหลักการทำงานที่ไม่เหมือนใครในตลาดเครื่องฟอกอากาศ ในเรื่องฆ่าเชื้อถ้าผมแนะนำก็จะให้ Wellis เป็นอันดับ 1 ในตอนนี้ เพราะส่วนตัวใช้เครื่องฟอกอากาศมาแล้วหลายยี่ห้อ มียี่ห้อนี้แหละที่หลักการทำงานแตกต่างกันออกไปและงัดด้วยผลการวิจัยออกมาให้เห็นถึงประสิทธิภาพของตัวเครื่อง
แม้ว่า Wellis ยังอาจจะขาดฟังก์ชั่นประเภทพวกหน้าจอแสดงผล , การวัดค่าต่าง ๆ เป็นตัวเลข และเทคโนโลยีที่เชื่อมต่อกับ Smartphone แต่จากการใช้งานก็ดูไม่ค่อยจำเป็นเท่าใดนัก เพราะเครื่องออกแบบให้เปิดเอาไว้ตลอดเวลาอยู่แล้ว ซึ่งในจุดนี้อาจจะขัดใจคนที่ชอบดูตัวเลขที่วัดค่าได้นิดนึง แต่ถ้าอ่านจากเอกสารการทดสอบ ก็จะอุ่นใจได้เลยว่าเครื่องสามารถใช้งานได้ผลจริง โดยเฉพาะอย่างยิ่งช่วง Covid – 19 ระบาดแบบนี้ การมี Wellis ไว้ในบ้านหรือที่ทำงาน ก็ทำให้วางใจได้ในระดับหนึ่งเลยละครับ 🙂
สำหรับใครที่สนใจ Wellis ตัวนี้
ค่าตัวในราคาเต็มอยู่ที่ 29,900 บาท จัดจำหน่ายโดย Wellis Thailand official ซึ่งเป็นตัวแทนจำหน่ายอย่างเป็นทางการ ตัวเครื่องมีการรับประกัน 2 ปี มีปัญหาทาง Wellis เปลี่ยนตัวใหม่ให้เลย
และทาง Wellis มักออกโปรโมชั่นมาให้ติดตามกันอยู่เรื่อย ๆ โดยสามารถติดตามโปรโมชั่นและช่องทางการสั่งซื้อได้ที่ด้านล่างนี้ครับ
Website : https://www.wellisofficialthailand.com/
Facebook : https://www.facebook.com/wellisth/
Lazada : https://s.lazada.co.th/s.8ZbmW
Shopee : https://shopee.co.th/wellisthailandofficial?categoryId=12996&itemId=5734602639
ในปัจจุบันมีของปลอมและของลอกเลียนแบบออกมา น้ำยาที่นำมาใช้ก็อาจจะเป็นอันตราย ไม่สามารถฆ่าเชื้อโรคได้จริง และเมื่อเครื่องชำรุดเสียหายแน่นอนว่า Wellis ไม่รับซ่อมนะครับ
โดยวิธีการตรวจสอบตัวแทนจำหน่ายสามารถสอบถามได้ที่
Line ID : @wellisthailand
ถ้าไม่มั่นใจอันไหนจริงอันไหนปลอมก็สั่งซื้อตามช่องทางด้านบน อุ่นใจกว่าทั้งเรื่องการให้ข้อมูลที่ถูกต้องและของจริงมีคุณภาพ มีการรับประกันและการดูแลหลังการขายครับ 🙂





